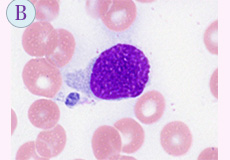

今回は、前回に続き「いだてん(韋駄天)」について、お話したいと思います。野球好きな私にとって、プロ野球界における“韋駄天”とは、元南海ホークス(現在の福岡ソフトバンクホークス)の広瀬叔功氏(現在82歳)が思い出されます。
広瀬氏は、通算22年間の選手生活の中で歴代2位の596盗塁と2,157安打により、名球会入りを果たした往年の名選手です。また、1961年から5年連続盗塁王を獲得し、1964年に31連続盗塁成功(成功率82.9%)の日本記録を保持しています。現役時代の広瀬氏は、盗塁に対して強いこだわりがあり、試合の流れの中で、必要な場面でしか次の塁を狙いませんでした。通算596盗塁数でしたが、このこだわりがなければもっと大きな記録が誕生したかもしれません。尚、プロ野球の盗塁通算記録は、1位は福本豊氏(元 阪急ブレーブス;現在のオリックス・バファローズ)の1065個、2位は広瀬氏の596個、そして3位は柴田勲氏(元読売ジャイアンツ)の579個だそうです。尚、あのイチロー選手は、日米通算708盗塁を記録しています。
一方、盗塁成功率(生涯200盗塁以上)では、1位は広瀬氏82.89%、2位は「代走のスペシャリスト」鈴木尚弘氏(元 読売ジャイアンツ) 82.31%、3位は松井稼頭央氏(現 埼玉西武ライオンズ 二軍監督)81.86%です。ここからもいかに広瀬氏が、ワンチャンスにこだわった「イダテン」ぶりを確認することができます。
野球は、よく筋書きのないドラマと言われています。試合の結末は、9回を待たなければわかりません。また、試合の流れは、ホームランバッターによる一発逆転ホームランで流れを変えてしまう魅力もありますが、そう多くは望めるものではありません。やはり、ここは九回裏、二死一塁の場面で勝負に賭ける“こだわり” の 「イダテン」にドラマの結末を委ねてみたいものです。今年のプロ野球は3月29日に開幕します。皆さまも風にようにダイアモンドを駆け抜けていく「イダテン」を探しに、一度球場に足を運んでみませんか。
形態マガジン号キャプテン 阿南 建一 
今回は、細胞同定と症例検討を提示しました。
細胞同定は、骨髄における造血細胞と非造血細胞の形態所見の捉え方に挑戦します。
症例編は、わずかな臨床像と検査データから次なる検査を模索し、骨髄像から臨床診断を試みて下さい。
末梢血液像の細胞同定を行なって下さい。何か異常所見はありますか。
BM-MG×1000

BM-MG×1000

BM-MG×1000

BM-MG×1000

光顕的所見から臨床診断を考えて下さい。
【所見】
【40~45歳.女性】主訴:貧血、出血
WBC31,100/μL(Blast73%, Mo10%)、RBC172万/μL、Hb5.7g/dL、Ht17.1%、PLT1.4万/μL、NCC50.8万/μL
PB-MG×1000

BM-MG×1000

BM-PO×1000

BM-ESTdouble×600/PAS×1000

問題 1
骨髄の細胞同定を行なって下さい。
【解説】
BM-MG.1000

問題 2
30歳代.女性。発熱、貧血を主訴に来院されました。
【解説】
(PB-MG×400)

(BM-MG×1000)

(BM-MG/BM-PO×1000)

(BM-ACP/A-EST×1000)

これから先のページでは、医療関係者の方々を対象に医療機器・体外診断薬等の製品に関する情報を提供しております。当社製品を適正に使用していただくことを目的としており、一部の情報では専門的な用語を使用しております。
一般の方への情報提供を目的としたものではありませんので、ご了承ください。
医療関係者の方は、次のページへお進みください。
(お手数ですが、「進む」ボタンのクリックをお願いします)